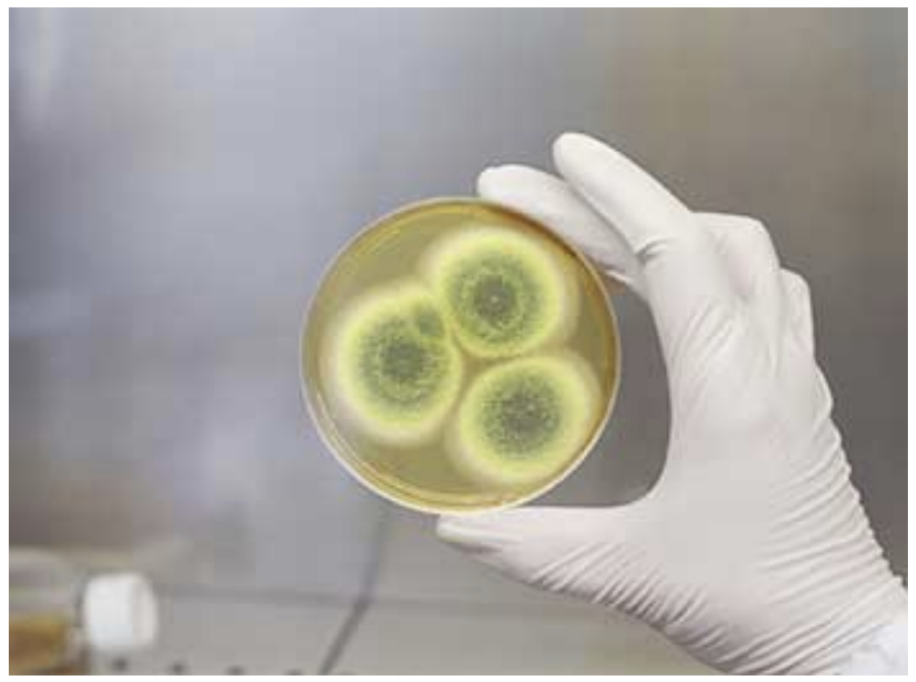

Moving tips - Mold & Mildew Cells
The risk coming from the aspects of mold & mildew
Shifting to a new house is an adventurous task, and problems come in hand in glove’ is what an old saying goes. One such overlooked but very crucial area associated with moving, more so in humid climates, is the risk posed by mold and mildew. It is these fungi that can damage a lot of your personal effects, particularly clothing, leather goods, and paper-based objects. At Asian Tigers, we know the importance of safeguarding your valued belongings from these organisms. The following content provides some useful tips on how to prevent mold and mildew during your move and what can be done in case the goods are damaged.
Understanding Mold and Mildew
Mold and mildew are types of fungus that grow in especially moist, humid conditions. They reproduce by means of tiny, airborne spores that easily adhere to wet surfaces before germination and spreading. While growing, they can discolor materials, generate foul odors, and damage your possessions beyond repair.
When mold and mildew start to grow on cloth materials, they start destroying the fabric, resulting in such fabrics being more susceptible to rupture and wearing out. Moldy leather goods can grow musty and brittle, and develop a color change, loss of pliability, and a degraded texture quality. Paper products, such as books and documents, could be marred by warping, including browning and other stains that may render them unreadable, especially in worse cases. Very often, the damages caused by mildew and mold are permanent; which is why it is of utmost urgency to prevent the growth of these microorganisms to save your items.
Preventing Mold and Mildew During Your Move
Mold and mildew can never be prevented entirely, but the chances of damage during a move can be significantly reduced by using the following ways. Here is some advice from Asian Tigers to protect your stuff:
1. Consider the Climate
The first step to avoid mold and mildew is to consider the climate. When moving from or to a tropical or humid area, the chance of mold and mildew goes up drastically. In such conditions, one must be considerate regarding the planning of the weather while moving.
Asian Tigers also encourages customers to pay attention to the weather and avoid packing during the most humid times of the day. Generally, the most humid part of the day is during the early morning and late afternoons; hence, it will be good to pack during the driest hours of the day, which will be during midday. If you pack strategically with the weather, you will have little exposure and least exposure to stuff and hence, lesser mold and mildew.
2. Correct Packing Materials
The packing material one uses will go a great way in the prevention of the formation of mold and mildew. Although plastic covers, it may seem, are right to ensure waterproofing; they can actually trap the moisture in one item and create the perfect condition for mold formation. Use breathable packing materials like cotton sheets and specially made covers which permit air circulation.
For highly sensitive items, such as clothing, leather, and paper, one should be employing packaging materials that are both protective and allow for ventilation. Acid-free tissue paper and muslin cloths are good for wrapping fragile items, as they help to absorb moisture without sealing it in.
3. Ensure Everything is Dry Before It is Packed
The best way of avoiding mold and mildew is to ensure that all your belongings are completely dry before packing. Even a tiny amount of moisture, when coupled with tightly packed items, can lead to mold growth during transit.
If you are not certain about this in your home, you should run a dehumidifier in the days before the move. It will help to remove excess moisture from the air, making your things dry. Special attention may be paid to such items that are susceptible to moisture as shoes and handbags, paper products, making sure that these are quite dry before packing.
4. Silica Gel Packets
These silica gel packets can be a very simple yet very effective way of prevention for dampness in closed spaces. These small pocket-sized pouches, containing a drying agent—silica, draw excess moisture from the atmosphere and therefore keep your stuff dry. When packing, place a few silica gel packets inside boxes holding particularly mold and mildew-prone items, such as leather goods and clothing.
Silica gel packets can come in especially handy when you’re packing things that are supposed to stay in storage over the long term or in the items for an international move where your goods are going to be in transit for a longer time.
5. Periodically Check Stored Items
If you have stored goods that need to be stored before you move, ensure you interrogate them regularly for signs of moisture or mold. Early detection can really help in avoiding large amounts of damage, and most important of all, you will be able to act before the damage extends.
When examining the items in storage, inspect them for any signs of discoloration, musty odors, or visible mold growth. Upon discovering any problems, discard the affected items immediately and undertake an effort to clean and dry anything else thoroughly before repacking.
Cleanup and Drying Procedures for Mold and Mildew-damaged Items
Even with best effort, at times mold and mildew damage can occur during the move. If you find yourself in this position, knowing precisely what to do to document the damage and how to file a claim is important.
1. Document the Damage
First, when you find mold and mildew damage in your materials, be certain to document it. Take clear and explicit pictures of damaged items, note the extent of damage, and indicate any indication of mold or mildew on the items. Ensure to take the photos from multiple angles and include closeup pictures of the most hurt parts of each item.
Aside from the pictures, enumerate all damaged items with their descriptions of condition before moving and the level of damage when they were delivered. This will be important reference material to request reimbursement for any damage incurred.
2. Call Asian Tigers Immediately
Should you notice damage, alert Asian Tigers promptly. Our customer service officers will help you submit the claim by guiding and detailing to you everything that you need to do and specify. We understand that filing claims on damaged goods can be a frustrating process and, therefore, are ready to help at every step.
Besides that, Asian Tigers offer a wide range of protection, which includes damage resulting from mold and mildew. If it is covered in the policy, they will be able to pay for the repair or replacement of an item damaged by the same effect. Our team will help guide you through your claim process so that the experience is easy, free of hassle, and effective.
Before you move, ensure to review a moving insurance policy to ascertain that you will have enough coverage against the potential risks, among them mold and mildew. If you are not confident that your insurance will cover you, relocation consultants available with our team can assist you in making the necessary changes in your insurance policy.
Conclusion: Mold and Mildew Protection for Possessions
Mildew and mold are a frequent menace to your possessions in a move, more so in a humid environment. Proper preventive measures greatly reduce the risks and help you settle in your new home without hitches. Asian Tigers deliver the most superior service and support to our clients. By following the suggestions and tips contained in this article, you will be much better prepared to keep your stuff mildew as well as mold free and significantly reduce the stress of the move.
If at any point during your move you find that you need assistance regarding mold and mildew, understand that we are always here to help walk you through the claim process and get you the information you need in a timely manner. We want to keep you at peace, and we want to make this move the safest and most secure process that it could possibly be.






